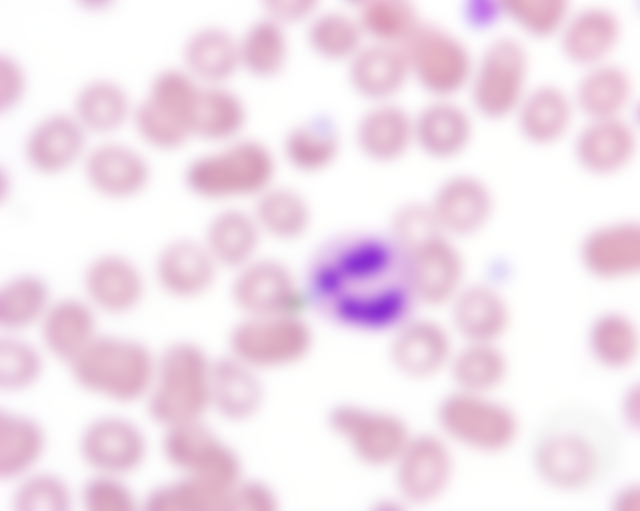

32.當犬貓有輕度毒血症時,嗜中性球細胞質內最易出現大小不一藍色角狀的包涵體為何者?
(A)Golgi bodies
(B)Pelger-Huet anomaly
(C)Döhle bodies
(D)Russell bodies
詳解 (共 7 筆)
未解鎖
(A)Golgi bodies 高基小...
未解鎖
Pelger-Huet anomaly ...
未解鎖
(A)Golgi bodies 高基氏體...
未解鎖
Russel body: plasma ...
未解鎖
藍本143

私人筆記 (共 1 筆)
未解鎖
https://imagebank.he...